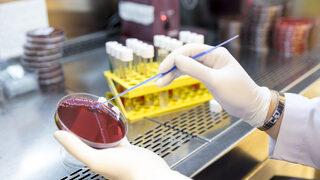
Dünya koronayı konuşuyor ama asıl tehlike kapıda: Bir çizik bile öldürebilir

Antibiyotik direnci haberleri sayfası, günümüzde sağlık alanında önemli bir yer tutan antibiyotik direnci konusundaki en güncel gelişmeleri takip etmenizi sağlıyor. Son yıllarda artan antibiyotik kullanımı, bakterilerin bu ilaçlara karşı direnç geliştirmesine yol açtı ve bu durum, küresel sağlık üzerindeki etkileriyle gündeme geldi. Burada, antibiyotik direnci ile ilgili son dakika haberleri ve bilimsel araştırmalar hakkında bilgileri bulabilirsiniz.
Kapsamlı bir şekilde sunduğumuz antibiyotik direnci haberleri, bu konuda farkındalığı artırmayı amaçlıyor. Antibiyotik direnç mekanizmaları, etkili tedavi yöntemleri ve sağlık kuruluşlarının bu soruna karşı aldığı önlemler gibi konular üzerine detaylı bilgilere ulaşmanız mümkün. Ayrıca, sağlık uzmanlarından ve araştırmalardan edinilen verilerle, antibiyotik direncinin önüne geçmek için neler yapılabileceği konusunda bilgilendirilmektedir.

Haber Gönder
Haber Gönder